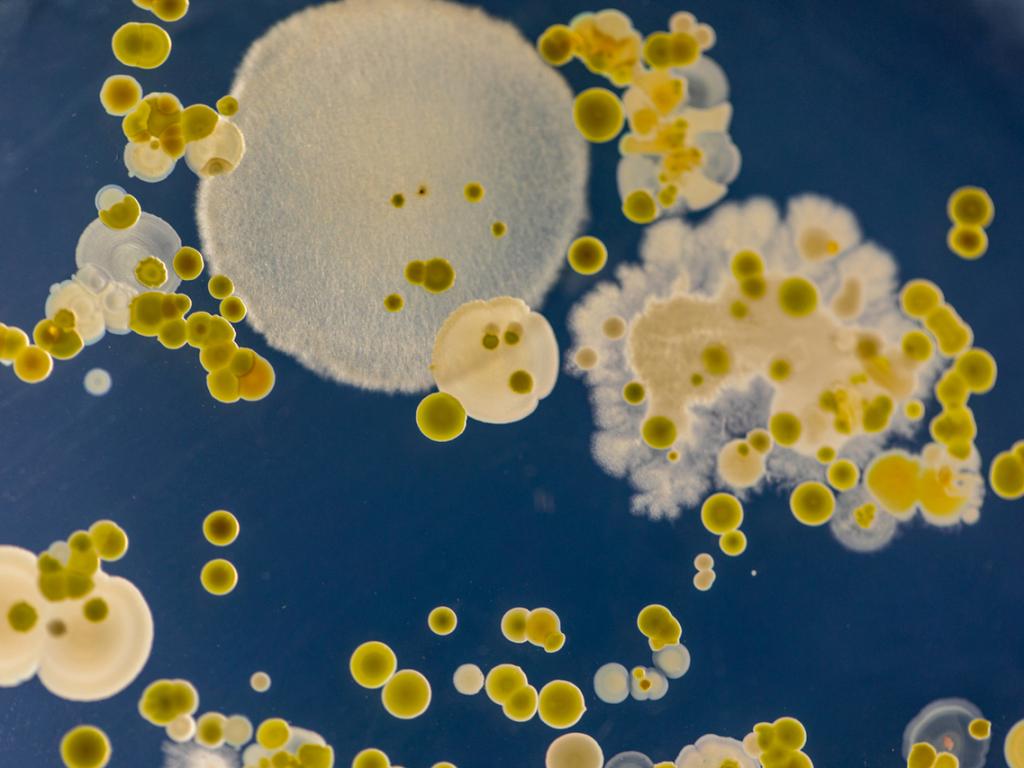
Трима гуляйджии бяха откарани в болница с гъбична треска от

... екипа за лайфстайл във Fox News Digital. Съвети за разкази могат да се изпращат на [email protected].Свързани темиЗДРАВЕ ИНФЕКЦИОННА БОЛЕСТ са болестиБолест НАЧИН НА ЖИВОТОКОЛНА СРЕДАБактерииВирусиКалифорния
Калифорния Фестивал - Новини
Посетители на фестивала внимавайте Калифорнийските здравни служители предупреждават че хиляди
...... можем да предприемем, за да намалим риска от треска от долината за бъдещи фестивални събития, и да направи информацията достъпна за тазгодишните присъстващи“, добави говорителят.
Трима гуляйджии бяха откарани в болница с гъбична треска от
...... обикновено чрез дейности като строителство, земеделие, събития на открито като фестивали или дори силни ветрове. California Festivalgoers Hospitalized with Fungal Valley Fever - Newsweek —
Има и ранени Най малко 10 души бяха убити а 9 бяха
...... жители с азиатски произход. От мястото на събитието репортер на Франс прес предаде за внушително полицейско присъствие, отцепване на района и кръжащи във въздуха вертолети.
Десет души загинаха късно снощи при масова стрелба в Калифорния
...... много азиатци. Вчера там започна двудневен фестивал, който е една от най-големите прояви по случай Лунната нова година в Южна Калифорния. Последвайте Епицентър.БГ вече и в и !
Десет души загинаха късно снощи при масова стрелба в Калифорния
...... dead — in the area of Garfield/Garvey where there was a Lunar New Year festival, which I attended with a few friends. — Facts Chaser
Девет души загинаха късно снощи при масова стрелба в Калифорния
...... 60 000 души. Там живеят много азиатци.Вчера там започна двудневен фестивал, който е една от най-големите прояви по случай Лунната нова година в Южна Калифорния.
Девет души са загинали при стрелба в калифорнийския град Монтерей
...... година е ежегодно събитие в Монтерей Парксъбитие, което протича два дни и привлича над 100 000 посетители. Градът е дом на голяма азиатска общност.Снимка: Ройтерс
Девет души са загинали при стрелба в калифорнийския град Монтерей
...... стрелбата, е арестуван. Фестивалът за китайската нова година е ежегодно събитие в Монтерей Парк, което продължава продължават през целия уикенд и привлича над 100 000 посетители.
Девет души загинаха късно снощи при масова стрелба в Калифорния
...... 000 души. Там живеят много азиатци. Вчера там започна двудневен фестивал, който е една от най-големите прояви по случай Лунната нова година в Южна Калифорния.
Девет души загинаха късно снощи при масова стрелба в Калифорния
...... 60 000 души. Там живеят много азиатци.Вчера там започна двудневен фестивал, който е една от най-големите прояви по случай Лунната нова година в Южна Калифорния.
Девет души са загинали при стрелба в калифорнийския град Монтерей
...... събитие в Монтерей Парксъбитие, което протича два дни и привлича над 100 000 посетители. Градът е дом на голяма азиатска общност. Снимка: Ройтерс Снимка: Ройтерс
Властите установиха самоличността на извършителя на нападението на фестивал в
...... простреляни или пострадали по друг начин при блъсканицата, когато хората са се опитвали да избягат, казаха органите на реда. Властите издирват заподозрян съучастник на стрелеца.
Най малко трима души са загинали а 16 са ранени след
...... хора. Има и пострадали деца.Засега повече подробности за евентуалните мотиви за стрелбата, станала в последния ден на фестивала, както и за задържания, не се съобщават.
Трима души са загинали при стрелба която мъж е открил
...... Очевидци разказват, че бял мъж на 30 и няколко години открил стрелба с пушка. Полицаи са се отзовали за по-малко от минута след първите изстрели.
Най малко четирима души са били убити при стрелба на традиционен
...... около 50 километра от Сан Хосе. Фестивалът там е традиционен, провежда се от 1979 година и продължава три дни. Основен "обект" на фестивала е чесънът.
Най малко трима души са убити при стрелба по време на
...... провежда ежегодно и продължава три дни.По време на събитието в град Гилрой, намиращ се на около 170 километра от Сан Франциско, се стичат хиляди хора.
Най малко трима души са били убити а 16 други ранени
...... все още не е задържан, написа още той. Градчето Гилрой, където се е разиграла трагедията, се намира на около 50 км от Сан Хосе. /news.bg
Най малко трима души са убити и няколко ранени при стрелба
...... Според медии на спасителните служби било съобщено, че 11 души били повалени на земята след като в последния ден на празника на чесъна отекнали изстрели.
Трима души загинаха а 11 са ранени при стрелба по
...... все още се издирва. Според свидетели той е бял мъж на видима възраст 30 години. Стрелецът е открил произволна стрелба, но мотивите му остават неясни.
Трима души са били убити при стрелбата в неделя на
...... щати, но въпреки мащаба на проблема с насилието в страната, усилията за неговото законодателно решаване отдавна се намират в задънена улица на федерално равнище. /БГНЕС
Най малко трима души са убити и няколко ранени при стрелба
...... с информация за състоянието им. На видеозаписи в социални медии се вижда как хора са се разбягали на празника и се опитват да се скрият.
По време на традиционен кулинарен фестивал в Гилрой щата Калифорния
...... @wavyia]#breaking #breakingnews #gilroy #gilroygarlicfestival pic.twitter.com/Bq44nIf1Ey — KSBW Action News 8 (@ksbw) 29 юли 2019 г. Гилрой се намира на около 50 километра от Сан Хосе.